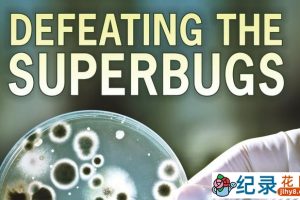
BBC防疫科普纪录片《战胜超级病菌 Defeating the Superbug》全1集 720P/1080i高清纪录片资源百度云盘下载

-
BBC生活纪录片《瘦身十律 10 Things You Need to Know About Losing Weight》全1集 标清纪录片百度云下载
每年都有数以百万计的人试图减肥,但大多都在重复失败。我们每天都在遭受节食和最新的如何保持苗条信息的轰炸。 But what really works?可到底哪些真的起作用呢? 在BBC《瘦身十律 10 Things You Need to Know About Losing Weight》…- 0
- 0
-
交换饮食计划真人秀《超大号与超小号 Supersize vs Superskinny》第7季中字 1080P高清自媒体解说素材百度云盘下载
交换饮食计划真人秀《超大号与超小号Supersize vs Superskinny》讲述饮食和极端饮食。显示的主要特征之一是每周超重和体重不足的人。两人被带到一家饲料诊所,在克里斯蒂安杰森(Christian Jessen)医生的监督下共同生活了5天,并交换了饮食。每个参与者都吃对方的饮食。在实验结束时,他们更好地了解了他们在另一个人身上消耗了多少。我看到的每一集都是让参与者分享一段经历,让他们有…- 0
- 0
-
探索频道两性教育纪录片《人体奇航》全3集 标清纪录片资源百度云盘下载
探索频道纪录片《人体奇航》运用先进的磁共振造影技术,完全纪录人类从异性相吸到交合、受孕及分娩的真实过程。为了筹拍工程浩大的《人体奇航》,Discovery耗时整整两年,全程在美拍摄制作,其中影像成像费用就超过两百五十万元美金。 运用最先进的显像技术,拍出异卵双胞胎从子宫着床开始,发展出不同性徵…- 1
- 0
-
人体微生物研究纪录片《体内的怪物 Monsters Inside Me》第1-4季中字 1080P高清自媒体解说素材百度云盘下载
人体微生物研究纪录片《体内的怪物 Monsters Inside Me》地球上一些最可怕的生物太小而看不见!寄生或病毒攻击就像身体内狂暴的过山车,能导致骇人的有时甚至是致命的变化。同时已知寄生虫会感染生物并控制它们的大脑功能,我们会是下一个目标吗?本系列节目中将从科学的视角出发,生动地讲述病人因身体不知不觉遭到入侵而饱受折磨的故事。- 0
- 0
-
吉尼斯世界纪录真人秀《全球奇人之最》第7季中字 1080高清纪录片解说素材百度云盘下载
吉尼斯世界纪录真人秀《全球奇人之最》网罗全球最稀奇古怪的奇人怪事,各种特异功能、一技之长、不可思议的事件都被影像纪录下来,并得到了吉尼斯世界纪录组织的官方认可。- 0
- 0
-
吉尼斯世界纪录真人秀《全球奇人之最》第8季中字 1080高清纪录片解说素材百度云盘下载
吉尼斯世界纪录真人秀《全球奇人之最》网罗全球最稀奇古怪的奇人怪事,各种特异功能、一技之长、不可思议的事件都被影像纪录下来,并得到了吉尼斯世界纪录组织的官方认可。- 0
- 0
-
BBC不孕不育治疗纪录片《婴儿制造者:生育诊所 Baby Makers The Fertility Clinic》全1集 标清纪录片资源百度云盘下载
生儿育女,繁衍下一代,是生物本能,也是人类情感、家庭和社会生活的需要。位于利物浦的翰威特生殖医学中心是英国最有名的生育诊疗所之一,在那里,西方的“送子观音”们,正利用先进的医疗手段,为求子心切而又无法自然受孕的家庭带来希望。。。 然而受孕与新生命的缔造,是精妙无比,无可替代的过程,当今人类…- 0
- 0
-
BBC两性纪录片《性、死亡与生命的意义》全3集中字 标清纪录片资源百度云盘下载
BBC两性纪录片《性、死亡与生命的意义 Dawkins: Sex, Death and the Meaning of Life 2012》几千年前,人类就开始思考灵魂、来世、罪孽和上帝旨意等问题。宗教仪式仍然出现在我们的重大活动中。在这个发人深省的系列影片中,进化生物学家理查德?道金斯提出了一个问题:如果没有宗教,会发生什么?他分析了理性和科学对人类生活的激励和引导。科学是否能帮助我们理解死亡?帮…- 2
- 0
-
人脑奥秘纪录片《我是人类 I Am Human》全1集中字 1080P纪录片资源百度云盘下载
人脑奥秘纪录片《我是人类 I Am Human 2019》见见世界上第一个“电子人”——一个四肢瘫痪的人,一个盲人,一个截肢的人,一个生物黑客,还有一个患有帕金森症的女人——帮助他们的科学家们,还有一个为了解开大脑的奥秘而不惜一切代价的企业家们。- 0
- 0
-
探索频道人体探秘纪录片 《人体:挑战极限 Human Body Pushing the Limits》全4集 720P/1080i高清纪录片百度云下载
探索频道《人体:挑战极限 Human Body: Pushing the Limits》 将以前所未见的深入角度探索人体-人体在危机时刻如何因应?当生存本能涌现时,细胞与纤维又怎反应? 成年人体自有其独特之处,让我们成为地球上最优异的物种,更使我们得以统御自然界。它让我们足以超越地球极限,…- 0
- 0
-
交换饮食计划真人秀《超大号与超小号 Supersize vs Superskinny》第5季中字 1080P高清自媒体解说素材百度云盘下载
交换饮食计划真人秀《超大号与超小号Supersize vs Superskinny》讲述饮食和极端饮食。显示的主要特征之一是每周超重和体重不足的人。两人被带到一家饲料诊所,在克里斯蒂安杰森(Christian Jessen)医生的监督下共同生活了5天,并交换了饮食。每个参与者都吃对方的饮食。在实验结束时,他们更好地了解了他们在另一个人身上消耗了多少。我看到的每一集都是让参与者分享一段经历,让他们有…- 0
- 0
-
吉尼斯世界纪录真人秀《全球奇人之最》第1季中字 1080高清纪录片资源百度云盘下载
吉尼斯世界纪录真人秀《全球奇人之最》网罗全球最稀奇古怪的奇人怪事,各种特异功能、一技之长、不可思议的事件都被影像纪录下来,并得到了吉尼斯世界纪录组织的官方认可。- 1
- 0
-
BBC生命科学纪录片《人体奥秘 Inside the Human Body》全4集 720P/1080i高清纪录片百度云
纪录片《人体奥秘 Inside the Human Body》 本系列影片将带领我们探索人体的奥秘。根据真实的影像和最新的科学研究,使用惊人的图像技术来呈现。影片将带领观众踏上人体之旅,一窥人类体内神奇宇宙的运作。镜头穿梭于人体之间,从如同森林一般的细小绒毛群到心室扩张就像巨大教堂的心脏。为了阐明身体运作的惊人方式,本系列影片也讲述了世界各地,…- 0
- 0
-
吉尼斯世界纪录真人秀《全球奇人之最》第6季中字 1080高清纪录片解说素材百度云盘下载
吉尼斯世界纪录真人秀《全球奇人之最》网罗全球最稀奇古怪的奇人怪事,各种特异功能、一技之长、不可思议的事件都被影像纪录下来,并得到了吉尼斯世界纪录组织的官方认可。- 0
- 0
-
吉尼斯世界纪录真人秀《全球奇人之最》第9季中字 1080高清纪录片解说素材百度云盘下载
吉尼斯世界纪录真人秀《全球奇人之最》网罗全球最稀奇古怪的奇人怪事,各种特异功能、一技之长、不可思议的事件都被影像纪录下来,并得到了吉尼斯世界纪录组织的官方认可。- 0
- 0
-
PBS宇宙探索纪录片《太空一年 A Year in Space》全1集 720P/1080i高清纪录片百度云
PBS宇宙探索纪录片《太空一年 A Year in Space》 在国际太空站逗留近1年的美国太空人凯利和俄罗斯太空人科尔尼延科,昨天联同另一俄太空人沃尔科夫,乘坐「联盟TMA-18M」号太空船安全返抵地球,凯利更以340天,创下美国太空人单次逗留太空时间最长纪录,为未来火星载人任务铺路。 …- 0
- 0
-
吉尼斯世界纪录真人秀《全球奇人之最》第3季中字 1080高清纪录片解说素材百度云盘下载
吉尼斯世界纪录真人秀《全球奇人之最》网罗全球最稀奇古怪的奇人怪事,各种特异功能、一技之长、不可思议的事件都被影像纪录下来,并得到了吉尼斯世界纪录组织的官方认可。- 1
- 0
-
研究人体摄入糖类食品纪录片《另类糖影 That Sugar Film》全1集 720P/1080i高清纪录片资源百度云盘下载
文章目录[隐藏]糖类食品纪录片《另类糖影 That Sugar Film》糖类食品纪录片《另类糖影 That Sugar Film》 为了切断所有相冲突的科学观点,也为了即将到来的为人之父做准备,Damon Gameau决定找出糖对人体健康的真正作用。 Damon Gameau是一名澳大利亚…- 0
- 0
-
BBC抗抑郁纪录片《相信我.我是医生:心理健康特集》全1集原版无字 720P高清纪录片资源百度云盘下载
BBC抗抑郁纪录片《相信我.我是医生:心理健康特集》讲述压力、焦躁是现代人的常见病,美食是否能缓解压力,抗抑郁药是否有风险,家族病史有多大影响,Michael Mosley带领医生团队答疑解惑。- 0
- 0
-
交换饮食计划真人秀《超大号与超小号 Supersize vs Superskinny》第3季中字 720P高清自媒体解说素材百度云盘下载
交换饮食计划真人秀《超大号与超小号Supersize vs Superskinny》讲述饮食和极端饮食。显示的主要特征之一是每周超重和体重不足的人。两人被带到一家饲料诊所,在克里斯蒂安杰森(Christian Jessen)医生的监督下共同生活了5天,并交换了饮食。每个参与者都吃对方的饮食。在实验结束时,他们更好地了解了他们在另一个人身上消耗了多少。我看到的每一集都是让参与者分享一段经历,让他们有…- 0
- 0
-
Netflix人体奥秘纪录片《愉悦法则 The Principles of Pleasure》全3集中字 1080P纪录片资源百度云盘下载
Netflix人体奥秘纪录片《愉悦法则 The Principles of Pleasure 2022》欢愉感和现代科学共同开启女性愉悦领域之门,并打破古老的迷思。对数个世纪来的禁忌与误解抽丝剥茧,探讨迈向身体欢愉的各种途径。- 0
- 0
-
CCTV央视生命探索纪录片《人体星球 You Planet》全1集 720P/1080i高清纪录片百度云下载
任何时刻,我们的身体都寄生有100万亿种生物,大部分是我们肉眼无法看到的。平均每个人身上都有4磅外来生物,存在于身体的角落和缝隙。科学家们已发现了超过1000种不同的生物物种,很多都是以前未知的。多数寄生在人身上的生物被证明是有益的,它们甚至帮助我们维持健康。 这是…- 0
- 0
-
BBC防疫科普纪录片《战胜超级病菌 Defeating the Superbug》全1集 720P/1080i高清纪录片资源百度云盘下载
在世界各地,我们已经看到流氓细菌的出现。 这些都是超级病菌,危险的细菌正在抵抗我们唯一的防御:抗生素。 在世界各地跟踪这些潜在杀手蔓延的科学家,研究人员正在开发击败这些超级细菌的新技术。 抗生素是人类医学史上的一大奇迹,自诞生以来拯救了无数生命。但如今,由于人们滥用抗生素、药厂随意排放污水…- 1
- 0
-
SBS韩国版走近科学纪录片《瞬间捕捉世界有奇事》第2季合309集中字 720P/1080i高清纪录片资源百度云盘下载
文章目录[隐藏]SBS韩国版走近科学纪录片《瞬间捕捉世界有奇事》第2季合309集SBS韩国版走近科学纪录片《瞬间捕捉世界有奇事》第2季合309集 SBS韩国版走近科学纪录片《瞬间捕捉世界有奇事》由诸多猎奇事件,奇人奇闻组合的一档科普纪实类节目,每集都会介绍世界各地不平凡的人和事物。【注】由于韩文标题看不太懂,第二季收集时一小部分内容可能会和第一…- 0
- 0
幸运之星正在降临...
点击领取今天的签到奖励!
恭喜!您今天获得了{{mission.data.mission.credit}}积分
我的优惠劵
-
¥优惠劵使用时效:无法使用使用时效:
之前
使用时效:永久有效优惠劵ID:×
没有优惠劵可用!